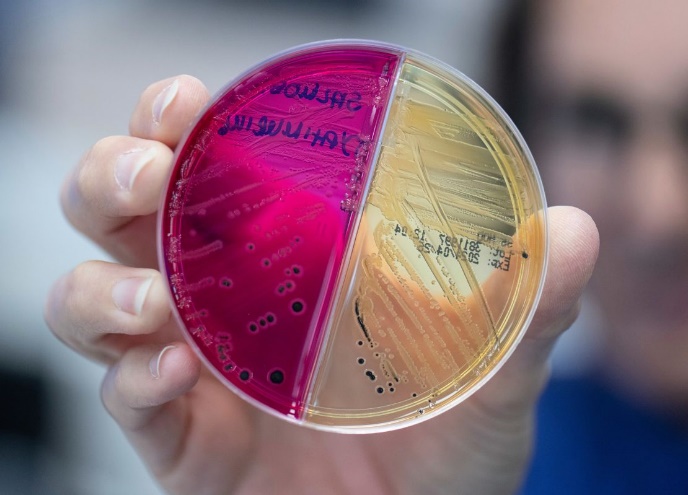
نوبل ۲۰۲۴؛ بارقهای از امید در جهانی پر از بحران و جنگ

به گزارش خبرنگار علم و فناوری ایسکانیوز؛ در آستانه برگزاری این مراسم بزرگ علمی گزارشی را میخوانید که گمانهزنیهایی از برندگان و همچنین استثنائاتی میپردازد که در این جایزه وجود داشته است. فصل جدید جایزه نوبل روز دوشنبه آینده با جایزه فیزیولوژی یا پزشکی آغاز میشود. به طور کلی، برندگان این جوایز بین هفتم تا ۱۴ اکتبر اعلام خواهند شد.
جایزه نوبل فیزیولوژی یا پزشکی روز دوشنبه اعلام میشود و پس از آن جایزه فیزیک روز سه شنبه و جایزه نوبل شیمی روز چهارشنبه اعلام میشود. جایزه نوبل ادبیات روز پنجشنبه و جایزه صلح نوبل روز جمعه اعلام خواهد شد.
آلفرد نوبل بعد از اینکه جایزه نوبل را برای تمام جهان به میراث گذاشت، در وصیتنامه خود در سال ۱۸۹۵ اعلام کرد این جوایز باید به کسانی تعلق گیرد که بزرگترین منفعت را به بشریت بخشیدهاند. از این رو «دن اسمیت»، رئیس موسسه تحقیقات صلح بینالمللی استکهلم، میگوید که با توجه به وضعیت تیره و تار جهان امروز، شاید هیچ کس نباید امسال جایزه صلح را دریافت کند.
به گفته او، بسیاری از مردم بسیار سخت کار میکنند و به هیچ جایی هم نمیرسند. ما به افراد و رهبران جهانی بیشتری نیاز داریم تا بیدار شوند و به عمق فاجعه زندگی انسانها پی ببرند.
او میگوید: ما اکنون بیش از ۵۰ درگیری مسلحانه در سراسر جهان داریم. مرگ و میر این درگیریهای مسلحانه در ۲ دهه گذشته به طرز چشمگیری افزایش یافته است.
با توجه به خطرات وجودی برای بشریت ناشی از سیستمهای تسلیحاتی که میتوانند به طور مستقل و بدون کنترل انسان عمل کنند، چندین ناظر نوبل از کمپین توقف رباتهای قاتل به عنوان برنده احتمالی نام بردهاند.
گروه تحلیلی «کلاریویت» که برندگان بالقوه علمی را رصد میکند، حدس میزند که یکی از جوایز نوبل میتواند به تحقیق در مورد ژنتیک متابولیسم لیپید اختصاص یابد که منجر به تولید داروهای جدید برای درمان بیماریهای قلبی عروقی شده است. یکی دیگر از کاندیدها میتواند مطالعات گانگلیونهای پایه باشد که بخشهایی از مغز هستند که با کنترل حرکتی و احساسات مرتبط هستند. یا این جایزه میتواند به کشف نقش ژنومی تعلق گیرد که درک ما از اپیژنتیک و رشد پستانداران را افزایش داده است.
سالی که هیچ کس برنده جایزه نوبل شیمی نشد
تصور کنید که به کل جامعه شیمی گفته شود که کارشان به اندازه کافی خوب نبوده است. چه اتفاقی میافتد؟ آیا این خبر روحیه شیمیدانها را تضعیف میکند یا به آنها انگیزه میدهد که برای بردن در این چالش بیشتر تلاش کنند؟
در سال ۱۹۲۴، دقیقاً این اتفاق رخ داد. ۳۵ دانشمند برای جایزه نوبل شیمی نامزد شدند، اما کمیته نوبل به جای انتخاب برنده، تصمیم گرفت جایزه آن سال را اعطا نکند.
این یک تصمیم نادر بود که تنها هشت بار در تاریخ اتفاق افتاده است و ۶ مورد آن به دلیل هرج و مرج جنگهای جهانی بود. علاوه بر این، جایزه نوبل شیمی در سال ۱۹۲۵ - قبل از اینکه در سال ۱۹۲۶ به «ریچارد زیگموندی:- یک سال به تعویق افتاد، اما باعث شد که شیمیدانان ۲ سال متوالی برای مشارکت در «منافع بزرگ برای بشریت» تلاش کنند.
از جمله نامزدهای سال ۱۹۲۴ «ژرژ اوربان» و «لیزه مایتنر» بودند. کارهای تحقیقاتی اوربان به طور گستردهای شناخته شد، زیرا او در تمام سالهای تحقیقاتی ش در مجموع ۵۶ بار نامزد جایزه نوبل شد، اما هرگز آن را دریافت نکرد. او روی کشف و جداسازی چندین عنصر کار کرد و در سال ۱۹۰۷ «لوتِتیُم» را کشف کرد. در سال ۱۹۲۲ نیز ادعا کرد که عنصر ۷۲ را کشف کرده است که او آن را «سلتیوم» نامید و طیف گسیلی کاملا مشخصی را منتشر کرد. با این حال، او به اشتباه آن را یک عنصر خاکی کمیاب معرفی کرد و طیفی که او مشخص کرده بود با عنصر واقعی ۷۲ تطابق نداشت. همین خطا باعث شد که کارهای تحقیقاتی جالب او تحت تاثیر قرار بگیرند و جایزه نوبل سال ۱۹۲۴ به او تعلق نگیرد.
لیز مایتنر بعد از ماری کوری، دومین زنی بود که نامزد جایزه نوبل شد. علیرغم اینکه آلبرت اینیشتین او را «ماری کوری آلمان» خطاب میکرد، کسی نام او را نشنیده بود. کارهای مایتنر به دلیل پیشداوری بیاهمیت جلوه داده شد.
مایتنر و «اتوهان» جزو اولین کسانی بودند که ایزوتوپ پروتاکتینیوم ۲۳۱ را در سال ۱۹۱۷ و ۱۹۱۸ جدا کردند و مایتنر در سال ۱۹۲۲ علت «اثر اوگر» را کشف کرد. این اکتشاف باید او را به یکی از نامزدهای جایزه نوبل تبدیل میکرد.
مایتنر بعداً با هان روی شکافت هستهای کار کرد و این فرضیه را مطرح کرد که هسته اورانیوم در طول شکافت هستهای به ۲ قسمت تقسیم میشود. با این حال، هان یافتههای خود را بدون ذکر اعتبار منتشر کرد و بعداً در سال ۱۹۴۴ برنده جایزه نوبل شد. در آن زمان، مایتنر در سوئد در تبعید زندگی میکرد، چون یهودی بود و از آلمان نازی گریخته بود. در واقع گفته میشود که جنسیت و مذهب او در عدم دریافت جایزه نوبل موثر بود. علاوه بر این، او از مشارکت در توسعه بمب هستهای خودداری کرد. همین امر نقشهان را پررنگتر کرد.
اخلاق تزلزلناپذیر مایتنر در طول این چالشها گواه بر انعطافپذیری و شایستگیهای اوست.
دادههای مربوط به تعداد پتنتها، نامزدهای جایزه نوبل و مقالات منتشر شده در مجلات شیمی که توسط مجله «وب آو ساینس» نمایه شدهاند، نشان میدهد که سال ۱۹۲۵ در هر سه مورد افت محسوسی در کارهای تحقیقاتی دانشمندان وجود داشته است. از این رو، در آن سال تعداد نامزدهای جایزه نوبل به کمترین میزان خود رسید و در دهه ۱۹۲۰ فقط ۲۵ نامزد جایزه نوبل انتخاب شد. البته باید گفت که عوامل بیرونی بسیاری وجود دارد که بر میزان بودجه یا فضای آزمایشگاهی در دسترس شیمیدانان تأثیر میگذارند و موجب این افت میشوند.
با این حال دادهها نشان میدهد که شیمیدانها یک سال پس از اینکه هیچ جایزه نوبلی به شیمیدانها تعلق نگرفت، افت شدیدی داشتند. مایتنر گفت علم به مردم میآموزد که واقعیت را بپذیرند و اگرچه این واقعیت مایوس کننده است، اما به نظر میرسید که فقدان جوایز نوبل دقیقاً همین کار را میکند.
جامعه علمی این را به عنوان واقعیت پذیرفت و برای غلبه بر این مشکل حتی سخت تر تلاش کرد. در سال ۱۹۲۵، «رنیم» کشف شد و فرآیند «فیشر-تروپش» به عنوان راهی برای ایجاد هیدروکربن توسعه یافت.
۵ اکتشاف شایسته نوبل که برنده جایزه نشدند
بهترین ذهنها در علم هفته آینده با اعلام جوایز نوبل در فیزیک، شیمی و فیزیولوژی یا پزشکی، از ابهام آکادمیک در کانون توجه قرار خواهند گرفت. پیشبینی اینکه چه کسی برنده افتخارات برتر علم خواهد شد، بسیار دشوار است. فهرست نامزدها محرمانه باقی مانده است و اسنادی که جزئیات فرآیند انتخاب را فاش میکند به مدت ۵۰ سال از دید عموم مهر و موم شده است.
با نزدیک شدن به اعلام برندگان جوایز نوبل، منبع خبرپراکنی سیانان گزارشی را منتشر کرده و به بررسی پنج پیشرفتی پرداخته است که با وجودی که در زمان خودشان بسیار متحول کننده و چشمگیر بودند، جایزه نوبل نگرفتهاند. در ادامه به آنها اشاره میکنیم:
اولین ژنوم انسان

یکی از نامزدهای مورد بحث برای دریافت جایزه نوبل، نقشهبرداری از ژنوم انسان است، پروژهای جسورانه که در سال ۱۹۹۰ راهاندازی شد و در سال ۲۰۰۳ تکمیل شد. شکستن کد ژنتیکی زندگی انسان شامل یک کنسرسیوم بینالمللی متشکل از هزاران محقق در آمریکا، بریتانیا، فرانسه، آلمان، ژاپن و چین بود.
این تلاش تأثیر گستردهای بر زیستشناسی، پزشکی و بسیاری از زمینههای دیگر داشت، اما یکی از دلایلی که این پروژه ممکن است جایزه نوبل را دریافت نکرده باشد، تعداد بسیار زیاد افراد درگیر در این شاهکار است.
براساس قوانینی که نوبل در وصیتنامه خود در سال ۱۸۹۵ وضع کرد، با توجه به ماهیت مشارکتی بسیاری از تحقیقات علمی، چالشی رو به رشد جوایز فقط میتوانند نهایتا به سه نفر اهدا شوند.
انقلابی در درمان چاقی

توسعه داروهای کاهش وزن پرفروش که هورمونی به نام «پپتید شبه گلوکاگون ۱» یا GLP-۱ را تقلید میکنند، در چند سال گذشته دنیای مراقبتهای بهداشتی را تکان داد. از هر هشت نفر در جهان یک نفر با چاقی دست و پنجه نرم میکند. این رقم از سال ۱۹۹۰ بیش از ۲ برابر شده است و دارویی که قند خون را کاهش میدهد و اشتها را کاهش میدهد، این پتانسیل را دارد که عصر جدیدی را برای درمان چاقی و شرایط مرتبط با آن آغاز کند.
سه دانشمند به نامهای «سوتلانا موژوف»، دکتر «جوئلهابنر» و «لوته نادسن» که در ساخت این دارو، معروف به سماگلوتید، شرکت داشتند، جایزه تحقیقات پزشکی بالینی لاسکر-دیباکی را در سال ۲۰۲۴ از آن خود کردند. این جایزه اغلب شاخصی در نظر گرفته میشود که آیا یک دانشمند خاص برنده جایزه نوبل میشود یا خیر.
موژوف بیوشیمیدان و دانشیار پژوهشی دانشگاه راکفلر و هابنر متخصص غدذ و استاد پزشکی دانشکده پزشکی هاروارد در بخش شناسایی و سنتز GLP-۱ نقش اساسی داشتند و نادسن، مشاور ارشد علمی در تحقیق و توسعه اولیه در شرکت داروسازی «نووو نوردیسک» در تبدیل آن به یک داروی موثر برای کاهش وزن. هماکنون میلیونها نفر از این دارو برای کاهش وزن استفاده میکنند.
هوش مصنوعی متحول کننده

هوش مصنوعی زندگی مردم را با سرعتی بیسابقه تغییر میدهد. این یک حوزه شلوغ است، اما ۲ نام برجسته در آن وجود دارد. کارشناسان با تجزیه و تحلیل تعداد دفعات استناد دانشمندان دیگر به مقالات علمی کلیدی در طول سالها، افراد «شایسته جایزه نوبل» را شناسایی میکنند.
چهرههای کلیدی عبارتند از «دمیس حسابیس» و «جان جامپر» که هر ۲ مخترع «دیپمایند گوگل» هستند. دیپمایند پایگاه داده ساختار پروتئین آلفا فولد است که یک برنامه هوش مصنوعی به شمار میرود که ساختارهای سهبعدی پروتئینها را از توالی اسیدهای آمینه رمزگشایی میکند. حداقل ۲ میلیون محقق در سراسر جهان از این ابزار استفاده کردهاند.
«آلفا فولد» به عنوان یک جستوجوگر گوگل برای ساختارهای پروتئین عمل میکند؛ به این شکل که دسترسی فوری به مدلهای پیشبینی شده پروتئینها، سرعت بخشیدن به پیشرفت در زیستشناسی بنیادی و سایر زمینههای مرتبط را فراهم میکند.
از زمانی که مقاله کلیدی این ۲ نفر در سال ۲۰۲۱ منتشر شد، بیش از ۱۳ هزار بار مورد استناد قرار گرفت که از نظر کارشناسان «عدد استثنایی» است. زیرا از مجموع ۶۱ میلیون مقاله علمی، تنها حدود ۵۰۰ مقاله بیش از ۱۰ هزار بار مورد استناد قرار گرفتهاند.
جامپر و حسابیس قبلاً جوایز لاسکر ۲۰۲۳ و «بریکترو» را بردهاند و بسیاری از کارشناسان حدس میزنند که جایزه نوبل شیمی امسال به این ۲ نفر برسد. البته برخی معتقدند که برای چنین جایزهای خیلی زود است، زیرا حوزه بسیار جدیدی است و هنوز هوش مصنوعی در تحقیقات علمی جایگاه خاصی به دست نیاورده است.
شناخت میکروبیوم روده
ما در بدنمان تنها نیستیم؛ تریلیونها میکروب، باکتری، ویروس و قارچ در بدنمان زندگی میکنند که در مجموع به عنوان میکروبیوم انسانی شناخته میشوند. با پیشرفتهایی در توالییابی ژنتیکی در ۲ دهه گذشته، دانشمندان بهتر توانستهاند بفهمند این میکروبها چه کار میکنند، چگونه با یکدیگر تعامل میکنند و با سلولهای انسانی، به ویژه در روده، تعامل دارند.
زیستشناس دکتر جفری گوردون، استاد برجسته دانشگاه دکتر رابرت جی. گلیزر در دانشگاه واشنگتن پیشگام این زمینه است. او تلاش کرد تا میکروبیوم روده انسان و چگونگی شکلدهی آن به سلامت انسان را درک کند و این کار را با تحقیقات آزمایشگاهی روی موشها شروع کرد. او تحقیقاتی را رهبری کرد که نشان داد میکروبیوم روده در تأثیرات سلامتی ناشی از سوء تغذیه، که تقریباً ۲۰۰ میلیون کودک را در سراسر جهان تحت تأثیر قرار میدهد، نقش دارد و او در حال توسعه مداخلات غذایی است که سلامت روده را بهبود میبخشد.
ژنهای سرطانزا

دانشمندان در دهه ۱۹۷۰ متوجه شدند که سرطان گاهی در چند عضو یک خانواده به وجود میآید و این در حالی بود که در مورد سرطان سینه این موضوع اصلا صادق نیست. «مری کلر کینگ»، که اکنون استاد پزشکی و علوم ژنوم در دانشکده پزشکی دانشگاه واشنگتن است، با پیشینه تحقیق در مورد تفاوتهای ژنتیکی بین انسان و شامپانزه رویکرد جدیدی را در پیش گرفت.
مدتها قبل از اینکه دانشمندان نقشهای از ژنوم انسان داشته باشند، کینگ ۱۷ سال را صرف کشف و شناسایی نقش جهش ژن BRCA۱ در سرطان سینه و تخمدان کرد. این کشف باعث توسعه آزمایشهای ژنتیکی شد که میتواند زنانی را که در معرض خطر ابتلا به سرطان سینه هستند و همچنین اقداماتی را که برای کاهش خطر آنها انجام دهند، مانند غربالگری اضافی و جراحیهای پیشگیرانه شناسایی کند.
انتهای پیام/
نظر شما